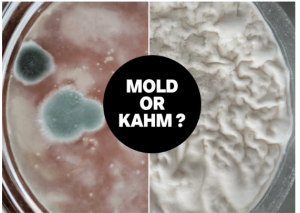

تفاوت کپک ولایه سفید روی سبزیجات تخمیری
درب قوطی خوراکی را پس از چند روزی باز می کنید و لایه ای سفید بر روی آن می بینید. حالا چند سوال به ذهن خطور می کند: آیا لایه سفید رنگ را جدا کنیم و محصول قابل استفاده است؟ یا محصول را کاملا دور بریزیم؟ یا می توان حتی آن لایه سفید رنگ را نیز مصرف کرد؟ در این نوشته قصد داریم به پاسخ این سوالات بپردازیم .
لایه سفید روی محصولات خوراکی می تواند چند چیز باشد که مهمترین و شایعترین آن ها Kahm yeast و Moldاست؛ این دو تفاوت بسیاری با یکدیگر دارند، اولی بی ضرر و شاید مفید و دومی مضر است. اما چگونه این دو را از یکدیگر افتراق دهیم؟
Mold

Mold جزئی از محیط زیست طبیعی است و می تواند هرجایی یافت شود، در خانه یا خارج خانه! در واقع، Mold گونه از قارچ هاست که در هرجایی می تواند رشد کند. بهترین راه کنترل رشد و تکثیر Mold پیدا کردن منبع آن و جلوگیری از رطوبت است. این ماده می تواند به عنوان یک آلرژن باعث ایجاد حساسیت های مختلف در بدن شود. لمس پوستی یا استنشاق این ماده می تواند واکنش های حساسیتی و آلرژیک را در فعال کند، که از جمله علائم آن می توانیم به آبریزش بینی، قرمزی چشم و راش های پوستی اشاره نماییم. Mold همچنین می تواند باعث ایجاد حمله آسمی در افراد مبتلا به آسم شود. ( https://www.cdc.gov/mold/ و https://www.epa.gov/mold/mold-and-health )
همانطور که گفته شد، Mold هرجایی می تواند باشد، اما یکی از مهمترین موارد ایجاد Mold بر روی مواد غذایی است. محصولات استریل و پاستوریزه شده احتمال ایجاد Mold ندارند تا زمانی که پلمپ آن باز شود. اگر در قسمتی از خانه Mold رشد کرده باشد، احتمال رشد آن بر روی مواد غذایی بیشتر می شود. به همین دلیل توصیه می شود منبع های محیطی Mold در خانه را از بین ببریم. همچنین توصیه می شود پس از باز کردن پلمپ محصولات غذایی، هر چه سریعتر آن ها را مصرف نماییم.
Mold طیف رنگی گسترده ای دارد، از جمله سفید، سبز و مشکی. بافت این ماده می تواند پودری شکل یا سطحی ریش ریش یا پرز دار باشد.
Kahm Yeast
Kahm Yeast لایه ای نازک به رنگ سفید یا کرمی بر روی سطح مواد غذایی است. Kahm Yeast اکثرا بر سطح مایعات تخمیری از جمله کامبوچا، کفیر و سبزیجات تخمیری تشکیل می شود. در طی فرآیند تخمیر، لاکتوباسیلوس ها یا سایر پروبیوتیک ها در رقابت با سایر باکتری ها قند موجود در محیط را مصرف می کنند . همچنین در طی متابولیسم این باکتری ها، لاکتیک اسید تولید می شود. کمبود قند و محیط اسید باعث پیروزی گونه های پروبیوتیکی شده و سایر گونه های باکتریایی از بین می روند، اما مخمرهایی مثل Kahm Yeast در این محیط می توانند رشد کنند. پس تولید و تشکیل این مخمر در محصولات تخمیری کاملا عادی است. اما آیا مضر است؟ خیر! برعکس Mold ، Kahm Yeast مضر نیست، حتی می توان آن را خورد، اما باید با نشانه هایی که گفته شد، آن را به دقت از Mold افتراق دهیم.
با چه نشانه هایی Mold را از Kahm Yeast افتراق دهیم؟
| وِیژگی | Kahm Yeast | Mold |
| ظاهر | لایه ای نازک، سفید یا کرمی رنگ | لایه ای ضخیم تر با رنگ های متفاوت از جمله سیاه، سبز، سفید
|
| بافت | لایه ای نرم و نازک
یک دست است |
بافت کتونی شکل یا مویی و ریش ریش
تکه تکه است |
| الگوی رشد | فقط در سطح می مانند | می تواند به عمق بافت غذایی نفوذ کند |
| بو | بوی ملایم تر و اندکی ترش | بوی ناخوشایند |
علت لزج بودن آب محصول تخمیری بدون اینکه کپکی توش باشه چی هست؟ خراب شده؟
سلام وقت بخیر، خیر خراب نشده علتش رو داخل پیج اینستاگرام گفتیم.
سلام و وقت بخیر
ممنون از مطلب مفیدتون
لطفا آیدی پیج اینستاگرامتون و بفرمایید